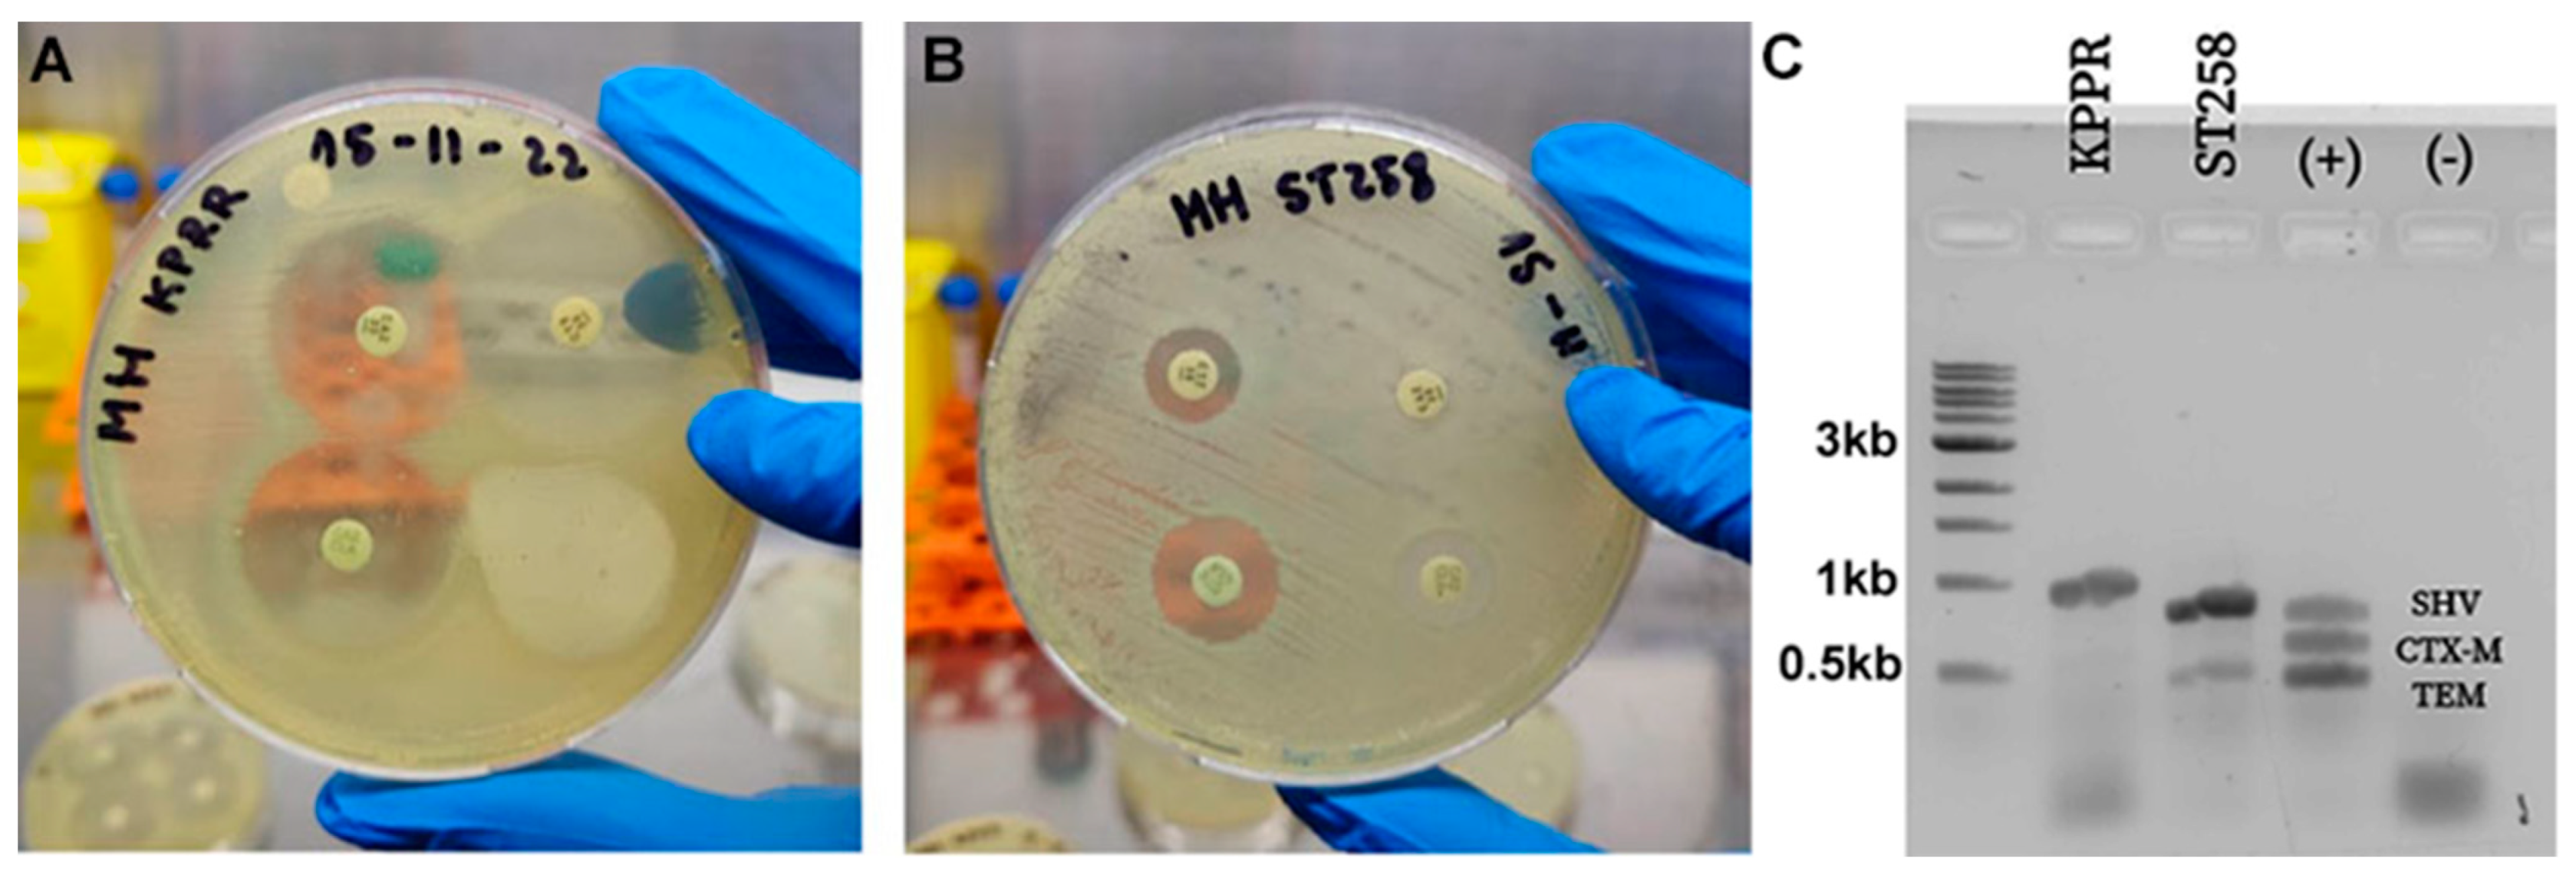
Ijms 26 04178 g002

Photodynamic Effectiveness of Copper-Iminopyridine Photosensitizers Coupled to Zinc Oxide Nanoparticles Against Klebsiella pneumoniae and the Bacterial Response to Oxidative Stress
Abstract
1. Introduction
2. Results
2.1. Synthesis and Structural Characterization of Photosensitizer and Nanoparticles Mix
2.1.1. Synthesis and Structural Characterization of Photosensitizers
2.1.2. Photophysical Characterization of Photosensitizers and Nanoparticles Mix
2.1.3. Synthesis of ZnONP
2.2. In Vitro Bacterial Susceptibility to Antibiotics
2.3. Antimicrobial Photodynamic Activity of Copper-Based Compounds
2.4. Photosensitizer Coupled to Zn Oxide Nanoparticles
2.5. Determination of the Minimum Inhibitory Concentration
2.6. Determination of the Adsorption Efficiency
2.7. Evaluation of the Mode of Action of PDT Using the PS/NP Mix
2.8. Determination of Cytotoxicity on Mammalian Cells of the CuC1 + ZnONP Mix
3. Discussion
4. Materials and Methods
4.1. Synthesis and Photophysical Characterization of the Photosensitizer Compounds
4.1.1. General Information and Materials
4.1.2. Synthesis and Characterization of the Copper(I) Compounds CuC1–3
4.2. Synthesis and Characterization of the Nanoparticles
4.3. Determination of Reactive Oxygen Species Production of PS/NP Mix
4.4. Phenotypic and Genotypic Characterization of Sensitivity of the Strains Used
4.5. Antimicrobial Activity of Photosensitizer Compounds/Nanoparticle Systems
4.6. Transcriptional Response to Stress
4.7. Cell Culture and Cytotoxicity Tests in Eukaryotic Cells
4.8. Statistical Analysis
5. Conclusions
Supplementary Materials
Author Contributions
Funding
Institutional Review Board Statement
Informed Consent Statement
Data Availability Statement
Acknowledgments
Conflicts of Interest
References
- Karampatakis, T.; Tsergouli, K.; Behzadi, P. Carbapenem-Resistant Klebsiella pneumoniae: Virulence Factors, Molecular Epidemiology and Latest Updates in Treatment Options. Antibiotics 2023, 12, 234. [Google Scholar] [CrossRef] [PubMed]
- Murray, C.J.; Ikuta, K.S.; Sharara, F.; Swetschinski, L.; Aguilar, G.R.; Gray, A.; Han, C.; Bisignano, C.; Rao, P.; Wool, E. Global burden of bacterial antimicrobial resistance in 2019: A systematic analysis. Lancet 2022, 399, 629–655. [Google Scholar] [CrossRef]
- Liu, Y.Y.; Wang, Y.; Walsh, T.R.; Yi, L.X.; Zhang, R.; Spencer, J.; Doi, Y.; Tian, G.; Dong, B.; Huang, X.; et al. Emergence of plasmid-mediated colistin resistance mechanism MCR-1 in animals and human beings in China: A microbiological and molecular biological study. Lancet Infect. Dis. 2016, 16, 161–168. [Google Scholar] [CrossRef]
- Willyard, C. The drug-resistant bacteria that pose the greatest health threats. Nature 2017, 543, 15. [Google Scholar] [CrossRef]
- WHO. WHO Priority Pathogens List for R&D of New Antibiotics. Available online: https://www.who.int/news/item/27-02-2017-who-publishes-list-of-bacteria-for-which-new-antibiotics-are-urgently-needed (accessed on 19 April 2021).
- Podschun, R.; Ullmann, U. Klebsiella spp. as nosocomial pathogens: Epidemiology, taxonomy, typing methods, and pathogenicity factors. Clin. Microbiol. Rev. 1998, 11, 589–603. [Google Scholar] [CrossRef] [PubMed]
- Echeverri-Toro, L.M.; Rueda, Z.V.; Maya, W.; Agudelo, Y.; Ospina, S. Multidrug-resistant Klebsiella pneumoniae, predisposing factors and associated mortality in a tertiary-care hospital in Colombia. Rev. Chil. Infectol. 2012, 29, 175–182. [Google Scholar] [CrossRef]
- Daikos, G.L.; Markogiannakis, A.; Souli, M.; Tzouvelekis, L.S. Bloodstream infections caused by carbapenemase-producing Klebsiella pneumoniae: A clinical perspective. Expert Rev. Anti-Infect. Ther. 2012, 10, 1393–1404. [Google Scholar] [CrossRef]
- Martin, R.M.; Bachman, M.A. Colonization, Infection, and the Accessory Genome of Klebsiella pneumoniae. Front. Cell. Infect. Microbiol. 2018, 8, 4. [Google Scholar] [CrossRef] [PubMed]
- Paczosa, M.K.; Mecsas, J. Klebsiella pneumoniae: Going on the Offense with a Strong Defense. Microbiol. Mol. Biol. Rev. MMBR 2016, 80, 629–661. [Google Scholar] [CrossRef]
- Pragasam, A.K.; Shankar, C.; Veeraraghavan, B.; Biswas, I.; Nabarro, L.E.; Inbanathan, F.Y.; George, B.; Verghese, S. Molecular Mechanisms of Colistin Resistance in Klebsiella pneumoniae Causing Bacteremia from India-A First Report. Front. Microbiol. 2016, 7, 2135. [Google Scholar] [CrossRef]
- Valenzuela-Valderrama, M.; Gonzalez, I.A.; Palavecino, C.E. Photodynamic treatment for multidrug-resistant Gram-negative bacteria: Perspectives for the treatment of Klebsiella pneumoniae infections. Photodiagnosis Photodyn. Ther. 2019, 28, 256–264. [Google Scholar] [CrossRef] [PubMed]
- Huang, L.; Dai, T.; Hamblin, M.R. Antimicrobial photodynamic inactivation and photodynamic therapy for infections. Methods Mol. Biol. 2010, 635, 155–173. [Google Scholar] [CrossRef]
- Agostinis, P.; Berg, K.; Cengel, K.A.; Foster, T.H.; Girotti, A.W.; Gollnick, S.O.; Hahn, S.M.; Hamblin, M.R.; Juzeniene, A.; Kessel, D.; et al. Photodynamic therapy of cancer: An update. CA Cancer J. Clin. 2011, 61, 250–281. [Google Scholar] [CrossRef] [PubMed]
- Yang, S.K.; Yusoff, K.; Thomas, W.; Akseer, R.; Alhosani, M.S.; Abushelaibi, A.; Lim, S.H.; Lai, K.S. Lavender essential oil induces oxidative stress which modifies the bacterial membrane permeability of carbapenemase producing Klebsiella pneumoniae. Sci. Rep. 2020, 10, 819. [Google Scholar] [CrossRef] [PubMed]
- Muskovic, M.; Planinic, M.; Crepulja, A.; Lusic, M.; Glad, M.; Loncaric, M.; Malatesti, N.; Gobin, I. Photodynamic inactivation of multidrug-resistant strains of Klebsiella pneumoniae and Pseudomonas aeruginosa in municipal wastewater by tetracationic porphyrin and violet-blue light: The impact of wastewater constituents. PLoS ONE 2023, 18, e0290080. [Google Scholar] [CrossRef]
- McKenzie, L.K.; Bryant, H.E.; Weinstein, J.A. Transition metal complexes as photosensitisers in one-and two-photon photodynamic therapy. Coord. Chem. Rev. 2019, 379, 2–29. [Google Scholar] [CrossRef]
- Monro, S.; Colon, K.L.; Yin, H.; Roque, J., 3rd; Konda, P.; Gujar, S.; Thummel, R.P.; Lilge, L.; Cameron, C.G.; McFarland, S.A. Transition Metal Complexes and Photodynamic Therapy from a Tumor-Centered Approach: Challenges, Opportunities, and Highlights from the Development of TLD1433. Chem. Rev. 2019, 119, 797–828. [Google Scholar] [CrossRef]
- Gourdon, L.; Cariou, K.; Gasser, G. Phototherapeutic anticancer strategies with first-row transition metal complexes: A critical review. Chem. Soc. Rev. 2022, 51, 1167–1195. [Google Scholar] [CrossRef]
- Wang, Y.; Tang, T.; Yuan, Y.; Li, N.; Wang, X.; Guan, J. Copper and Copper Complexes in Tumor Therapy. ChemMedChem 2024, 19, e202400060. [Google Scholar] [CrossRef]
- Lin, R.K.; Chiu, C.I.; Hsu, C.H.; Lai, Y.J.; Venkatesan, P.; Huang, P.H.; Lai, P.S.; Lin, C.C. Photocytotoxic Copper(II) Complexes with Schiff-Base Scaffolds for Photodynamic Therapy. Chemistry 2018, 24, 4111–4120. [Google Scholar] [CrossRef]
- Garin, C.; Alejo, T.; Perez-Laguna, V.; Prieto, M.; Mendoza, G.; Arruebo, M.; Sebastian, V.; Rezusta, A. Chalcogenide nanoparticles and organic photosensitizers for synergetic antimicrobial photodynamic therapy. J. Mater. Chem. B 2021, 9, 6246–6259. [Google Scholar] [CrossRef] [PubMed]
- Shi, L.E.; Li, Z.H.; Zheng, W.; Zhao, Y.F.; Jin, Y.F.; Tang, Z.X. Synthesis, antibacterial activity, antibacterial mechanism and food applications of ZnO nanoparticles: A review. Food Addit. Contam. Part A Chem. Anal. Control Expo. Risk Assess. 2014, 31, 173–186. [Google Scholar] [CrossRef]
- Bekmukhametova, A.; Ruprai, H.; Hook, J.M.; Mawad, D.; Houang, J.; Lauto, A. Photodynamic therapy with nanoparticles to combat microbial infection and resistance. Nanoscale 2020, 12, 21034–21059. [Google Scholar] [CrossRef] [PubMed]
- Yeh, Y.C.; Creran, B.; Rotello, V.M. Gold nanoparticles: Preparation, properties, and applications in bionanotechnology. Nanoscale 2012, 4, 1871–1880. [Google Scholar] [CrossRef] [PubMed]
- Singh, P.; Pandit, S.; Mokkapati, V.; Garg, A.; Ravikumar, V.; Mijakovic, I. Gold Nanoparticles in Diagnostics and Therapeutics for Human Cancer. Int. J. Mol. Sci. 2018, 19, 1979. [Google Scholar] [CrossRef]
- Tawfik, A.A.; Alsharnoubi, J.; Morsy, M. Photodynamic antibacterial enhanced effect of methylene blue-gold nanoparticles conjugate on Staphylococcal aureus isolated from impetigo lesions in vitro study. Photodiagnosis Photodyn. Ther. 2015, 12, 215–220. [Google Scholar] [CrossRef]
- Chen, M.; Long, Z.; Dong, R.; Wang, L.; Zhang, J.; Li, S.; Zhao, X.; Hou, X.; Shao, H.; Jiang, X. Titanium Incorporation into Zr-Porphyrinic Metal-Organic Frameworks with Enhanced Antibacterial Activity against Multidrug-Resistant Pathogens. Small 2020, 16, e1906240. [Google Scholar] [CrossRef]
- Khan, S.; Khan, S.N.; Meena, R.; Dar, A.M.; Pal, R.; Khan, A.U. Photoinactivation of multidrug resistant bacteria by monomeric methylene blue conjugated gold nanoparticles. J. Photochem. photobiology. B Biol. 2017, 174, 150–161. [Google Scholar] [CrossRef]
- Zheng, M.; Storz, G. Redox sensing by prokaryotic transcription factors. Biochem. Pharmacol. 2000, 59, 1–6. [Google Scholar] [CrossRef]
- Gort, A.S.; Ferber, D.M.; Imlay, J.A. The regulation and role of the periplasmic copper, zinc superoxide dismutase of Escherichia coli. Mol. Microbiol. 1999, 32, 179–191. [Google Scholar] [CrossRef]
- Licht, M.K.; Nuss, A.M.; Volk, M.; Konzer, A.; Beckstette, M.; Berghoff, B.A.; Klug, G. Adaptation to Photooxidative Stress: Common and Special Strategies of the Alphaproteobacteria Rhodobacter sphaeroides and Rhodobacter capsulatus. Microorganisms 2020, 8, 283. [Google Scholar] [CrossRef] [PubMed]
- Glaeser, J.; Nuss, A.M.; Berghoff, B.A.; Klug, G. Singlet oxygen stress in microorganisms. Adv. Microb. Physiol. 2011, 58, 141–173. [Google Scholar] [CrossRef]
- Seo, J.H.; Hong, J.S.; Kim, D.; Cho, B.K.; Huang, T.W.; Tsai, S.F.; Palsson, B.O.; Charusanti, P. Multiple-omic data analysis of Klebsiella pneumoniae MGH 78578 reveals its transcriptional architecture and regulatory features. BMC Genom. 2012, 13, 679. [Google Scholar] [CrossRef] [PubMed]
- Hormazábal, D.B.; Reyes, A.B.; Castro, F.; Cabrera, A.R.; Dreyse, P.; Melo-Gonzalez, F.; Bueno, S.M.; Gonzalez, I.A.; Palavecino, C.E. Synergistic effect of Ru(II)-based type II photodynamic therapy with cefotaxime on clinical isolates of ESBL-producing Klebsiella pneumoniae. Biomed. Pharmacother. 2023, 164, 114949. [Google Scholar] [CrossRef]
- Gonzalez, I.A.; Palavecino, A.; Nunez, C.; Dreyse, P.; Melo-Gonzalez, F.; Bueno, S.M.; Palavecino, C.E. Effective Treatment against ESBL-Producing Klebsiella pneumoniae through Synergism of the Photodynamic Activity of Re (I) Compounds with Beta-Lactams. Pharmaceutics 2021, 13, 1889. [Google Scholar] [CrossRef] [PubMed]
- Chiang, M.K.; Lu, M.C.; Liu, L.C.; Lin, C.T.; Lai, Y.C. Impact of Hfq on global gene expression and virulence in Klebsiella pneumoniae. PLoS ONE 2011, 6, e22248. [Google Scholar] [CrossRef]
- Moreno-da Costa, D.; Zuniga-Loyola, C.; Droghetti, F.; Robles, S.; Villegas-Menares, A.; Villegas-Escobar, N.; Gonzalez-Pavez, I.; Molins, E.; Natali, M.; Cabrera, A.R. Air- and Water-Stable Heteroleptic Copper (I) Complexes Bearing Bis(indazol-1-yl)methane Ligands: Synthesis, Characterisation, and Computational Studies. Molecules 2023, 29, 4020–4029. [Google Scholar] [CrossRef]
- Henriquez, M.A.; Engl, S.; Jaque, P.; Gonzalez, I.A.; Natali, M.; Reiser, O.; Cabrera, A.R. Phosphine evaluation on a new series of heteroleptic copper (I) photocatalysts with dpa ligand [Cu (dpa)(P, P)] BF4. Eur. J. Inorg. Chem. 2021, 2021, 4020–4029. [Google Scholar] [CrossRef]
- González, I.A.; Henríquez, M.A.; Cortés-Arriagada, D.; Natali, M.; Daniliuc, C.G.; Dreyse, P.; Maze, J.; Rojas, R.S.; Salas, C.O.; Cabrera, A.R. Heteroleptic Cu (I) complexes bearing methoxycarbonyl-imidoylindazole and POP ligands–an experimental and theoretical study of their photophysical properties. New J. Chem. 2018, 42, 12576–12586. [Google Scholar] [CrossRef]
- Navas, D.; Ibanez, A.; Gonzalez, I.; Palma, J.L.; Dreyse, P. Controlled dispersion of ZnO nanoparticles produced by basic precipitation in solvothermal processes. Heliyon 2020, 6, e05821. [Google Scholar] [CrossRef]
- Daumann, S.; Andrzejewski, D.; Di Marcantonio, M.; Hagemann, U.; Wepfer, S.; Vollkommer, F.; Bacher, G.; Epple, M.; Nannen, E. Water-free synthesis of ZnO quantum dots for application as an electron injection layer in light-emitting electrochemical cells. J. Mater. Chem. C 2017, 5, 2344–2351. [Google Scholar] [CrossRef]
- Sengar, P.; Garcia-Tapia, K.; Chauhan, K.; Jain, A.; Juarez-Moreno, K.; Borbón-Nuñez, H.A.; Tiznado, H.; Contreras, O.E.; Hirata, G.A. Dual-photosensitizer coupled nanoscintillator capable of producing type I and type II ROS for next generation photodynamic therapy. J. Colloid Interface Sci. 2019, 536, 586–597. [Google Scholar] [CrossRef]
- Yi, C.; Yu, Z.; Ren, Q.; Liu, X.; Wang, Y.; Sun, X.; Yin, S.; Pan, J.; Huang, X. Nanoscale ZnO-based photosensitizers for photodynamic therapy. Photodiagnosis Photodyn. Ther. 2020, 30, 101694. [Google Scholar] [CrossRef] [PubMed]
- Liu, Y.; Zhang, Y.; Wang, S.; Pope, C.; Chen, W. Optical behaviors of ZnO-porphyrin conjugates and their potential applications for cancer treatment. Appl. Phys. Lett. 2008, 92, 143901. [Google Scholar] [CrossRef]
- CLSI. Performance Standards for Antimicrobial Susceptibility Testing. In CLSI Supplement M100, 31st ed.; Clinical and Laboratory Standards Institute: Wayne, PA, USA, 2023. [Google Scholar]
- Monstein, H.J.; Ostholm-Balkhed, A.; Nilsson, M.V.; Nilsson, M.; Dornbusch, K.; Nilsson, L.E. Multiplex PCR amplification assay for the detection of blaSHV, blaTEM and blaCTX-M genes in Enterobacteriaceae. APMIS 2007, 115, 1400–1408. [Google Scholar] [CrossRef]
- Bogdan, J.; Plawinska-Czarnak, J.; Zarzynska, J. Nanoparticles of Titanium and Zinc Oxides as Novel Agents in Tumor Treatment: A Review. Nanoscale Res. Lett. 2017, 12, 225. [Google Scholar] [CrossRef] [PubMed]
- Lin, H.; Shen, Y.; Chen, D.; Lin, L.; Wilson, B.C.; Li, B.; Xie, S. Feasibility study on quantitative measurements of singlet oxygen generation using singlet oxygen sensor green. J. Fluoresc. 2013, 23, 41–47. [Google Scholar] [CrossRef]
- Bustamante, V.; Gonzalez, I.A.; Dreyse, P.; Palavecino, C.E. The mode of action of the PSIR-3 photosensitizer in the photodynamic inactivation of Klebsiella pneumoniae is by the production of type II ROS which activate RpoE-regulated extracytoplasmic factors. Photodiagnosis Photodyn. Ther. 2020, 32, 102020. [Google Scholar] [CrossRef]
- Oliver, P.; Peralta-Gil, M.; Tabche, M.L.; Merino, E. Molecular and structural considerations of TF-DNA binding for the generation of biologically meaningful and accurate phylogenetic footprinting analysis: The LysR-type transcriptional regulator family as a study model. BMC Genom. 2016, 17, 686. [Google Scholar] [CrossRef]
- Franken, N.A.; Rodermond, H.M.; Stap, J.; Haveman, J.; van Bree, C. Clonogenic assay of cells in vitro. Nat. Protoc. 2006, 1, 2315–2319. [Google Scholar] [CrossRef]
- Wang, G.; Zhao, G.; Chao, X.; Xie, L.; Wang, H. The Characteristic of Virulence, Biofilm and Antibiotic Resistance of Klebsiella pneumoniae. Int. J. Environ. Res. Public Health 2020, 17, 6278. [Google Scholar] [CrossRef] [PubMed]
- Wyres, K.L.; Lam, M.M.C.; Holt, K.E. Population genomics of Klebsiella pneumoniae. Nat. Rev. Microbiol. 2020, 18, 344–359. [Google Scholar] [CrossRef] [PubMed]
- Stokes, J.M.; MacNair, C.R.; Ilyas, B.; French, S.; Cote, J.P.; Bouwman, C.; Farha, M.A.; Sieron, A.O.; Whitfield, C.; Coombes, B.K.; et al. Pentamidine sensitizes Gram-negative pathogens to antibiotics and overcomes acquired colistin resistance. Nat. Microbiol. 2017, 2, 17028. [Google Scholar] [CrossRef] [PubMed]
- Nunez, C.; Palavecino, A.; Gonzalez, I.A.; Dreyse, P.; Palavecino, C.E. Effective Photodynamic Therapy with Ir(III) for Virulent Clinical Isolates of Extended-Spectrum Beta-Lactamase Klebsiella pneumoniae. Pharmaceutics 2021, 13, 603. [Google Scholar] [CrossRef]
- Cabrera, A.R.; Villasenor, E.; Werlinger, F.; Rojas, R.S.; Valderrama, M.; Antinolo, A.; Carrillo-Hermosilla, F.; Férnadez-Galan, R. Grafting of the zirconium complexes [Zr (η5-C5H5){NC-amidine}Cl2] and [Zr (η5-C5H5)(NC-NacNac)Cl2] and the study of their behavior in ethylene polymerization. J. Mol. Catal. A Chem. 2014, 391, 130–138. [Google Scholar] [CrossRef]
- Okuniewski, A.; Rosiak, D.; Chojnacki, J.; Becker, B. Coordination polymers and molecular structures among complexes of mercury (II) halides with selected 1-benzoylthioureas. Polyhedron 2015, 90, 47–57. [Google Scholar] [CrossRef]
- Hirotsu, M.; Kuwamura, N.; Kinoshita, I.; Kojima, M.; Yoshikawa, Y.; Ueno, K. Steric, geometrical and solvent effects on redox potentials in salen-type copper(II) complexes. Dalton Trans. 2009, 37, 7678–7683. [Google Scholar] [CrossRef]
- Huang, J.; Mara, M.W.; Stickrath, A.B.; Kokhan, O.; Harpham, M.R.; Haldrup, K.; Shelby, M.L.; Zhang, X.; Ruppert, R.; Sauvage, J.P.; et al. A strong steric hindrance effect on ground state, excited state, and charge separated state properties of a Cu(I)-diimine complex captured by X-ray transient absorption spectroscopy. Dalton Trans. 2014, 43, 17615–17623. [Google Scholar] [CrossRef]
- Chen, D.; Chai, W.-X.; Song, L. Syntheses, steric hindrance effects, luminescent properties and TD-DFT calculations for a series of copper (I) iodide coordination complexes. Transit. Met. Chem. 2018, 43, 517–527. [Google Scholar] [CrossRef]
- Li, R.; Huang, X.; Li, X.; Liu, H.; Zhou, J.; Shen, J. A multi-functional drug delivery nanosystem release of TLR-7 immunostimulant and OKT3 induced efficient cancer immunotherapy. Photodiagnosis Photodyn. Ther. 2023, 44, 103834. [Google Scholar] [CrossRef]
- Zhao, J.; Gao, Y.; Huang, R.; Chi, C.; Sun, Y.; Xu, G.; Xia, X.-H.; Gou, S. Design of near-infrared-triggered metallo-photosensitizers via a self-assembly-induced vibronic decoupling strategy. J. Am. Chem. Soc. 2023, 145, 11633–11642. [Google Scholar] [CrossRef] [PubMed]
- Zhao, X.; Cheng, H.; Wang, Q.; Nie, W.; Yang, Y.; Yang, X.; Zhang, K.; Shi, J.; Liu, J. Regulating photosensitizer metabolism with DNAzyme-loaded nanoparticles for amplified mitochondria-targeting photodynamic immunotherapy. ACS Nano 2023, 17, 13746–13759. [Google Scholar] [CrossRef]
- Harris, F.; Pierpoint, L. Photodynamic therapy based on 5-aminolevulinic acid and its use as an antimicrobial agent. Med. Res. Rev. 2012, 32, 1292–1327. [Google Scholar] [CrossRef] [PubMed]
- Miretti, M.; Clementi, R.; Tempesti, T.C.; Baumgartner, M.T. Photodynamic inactivation of multiresistant bacteria (KPC) using zinc(II)phthalocyanines. Bioorganic Med. Chem. Lett. 2017, 27, 4341–4344. [Google Scholar] [CrossRef] [PubMed]
- Nagar, V.; Singh, T.; Tiwari, Y.; Aseri, V.; Pandit, P.P.; Chopade, R.L.; Pandey, K.; Lodha, P.; Awasthi, G. ZnO Nanoparticles: Exposure, toxicity mechanism and assessment. Mater. Today Proc. 2022, 69, 56–63. [Google Scholar] [CrossRef]
- Tan, Y.; Sun, S.; Chen, D.; Qiu, H.; Zeng, J.; Wang, Y.; Zhao, H.; Gu, Y. Light delivery device modelling for homogenous irradiation distribution in photodynamic therapy of non-spherical hollow organs. Photodiagnosis Photodyn. Ther. 2021, 34, 102320. [Google Scholar] [CrossRef]
- Svanberg, K.; Bendsoe, N.; Axelsson, J.; Andersson-Engels, S.; Svanberg, S. Photodynamic therapy: Superficial and interstitial illumination. J. Biomed. Opt. 2010, 15, 041502. [Google Scholar] [CrossRef]
- Baran, T.M.; Foster, T.H. Comparison of flat cleaved and cylindrical diffusing fibers as treatment sources for interstitial photodynamic therapy. Med. Phys. 2014, 41, 022701. [Google Scholar] [CrossRef]
- Bagchi, D.; Dutta, S.; Singh, P.; Chaudhuri, S.; Pal, S.K. Essential dynamics of an effective phototherapeutic drug in a nanoscopic delivery vehicle: Psoralen in ethosomes for biofilm treatment. ACS Omega 2017, 2, 1850–1857. [Google Scholar] [CrossRef]
- Raju, P.; Deivatamil, D.; Martin Mark, J.A.; Jesuraj, J.P. Antibacterial and catalytic activity of Cu doped ZnO nanoparticles: Structural, optical, and morphological study. J. Iran. Chem. Soc. 2022, 19, 861–872. [Google Scholar] [CrossRef]
- Vibornijs, V.; Zubkins, M.; Strods, E.; Rudevica, Z.; Korotkaja, K.; Ogurcovs, A.; Kundzins, K.; Purans, J.; Zajakina, A. Analysis of antibacterial and antiviral properties of ZnO and Cu coatings deposited by magnetron sputtering: Evaluation of cell viability and ROS production. Coatings 2023, 14, 14. [Google Scholar] [CrossRef]
- Yang, F.; Song, Y.; Hui, A.; Mu, B.; Wang, A. Phyto-mediated controllable synthesis of ZnO clusters with bactericidal activity. ACS Appl. Bio. Mater. 2022, 6, 277–287. [Google Scholar] [CrossRef]
- Muller, K.M.; Berghoff, B.A.; Eisenhardt, B.D.; Remes, B.; Klug, G. Characteristics of Pos19—A Small Coding RNA in the Oxidative Stress Response of Rhodobacter sphaeroides. PLoS ONE 2016, 11, e0163425. [Google Scholar] [CrossRef]
- Glaeser, J.; Klug, G. Photo-oxidative stress in Rhodobacter sphaeroides: Protective role of carotenoids and expression of selected genes. Microbiology 2005, 151, 1927–1938. [Google Scholar] [CrossRef]
- Zheng, J.; Jung, S.; Ha, J.-H.; Jeong, Y. Locusta migratoria hydrolysates attenuate lipopolysaccharide (LPS)/D-Galactosamine (D-Gal)-induced cytotoxicity and inflammation in Hep G2 cells via NF-κB signaling suppression. Appl. Biol. Chem. 2024, 67, 49. [Google Scholar] [CrossRef]
- Costa, R.M.; Dias, M.C.; Alves, J.V.; Silva, J.L.M.; Rodrigues, D.; Silva, J.F.; Francescato, H.D.; Ramalho, L.N.; Coimbra, T.M.; Tostes, R.C. Pharmacological activation of nuclear factor erythroid 2-related factor-2 prevents hyperglycemia-induced renal oxidative damage: Possible involvement of O-GlcNAcylation. Biochem. Pharmacol. 2024, 220, 115982. [Google Scholar] [CrossRef] [PubMed]
- Edge, R.; Truscott, T.G. The Reactive Oxygen Species Singlet Oxygen, Hydroxy Radicals, and the Superoxide Radical Anion—Examples of Their Roles in Biology and Medicine. Oxygen 2021, 1, 77–95. [Google Scholar] [CrossRef]
- Szewczyk, G.; Mokrzynski, K.; Sarna, T. Generation of singlet oxygen inside living cells: Correlation between phosphorescence decay lifetime, localization and outcome of photodynamic action. Photochem. Photobiol. Sci. 2024, 23, 1673–1685. [Google Scholar] [CrossRef]
- Jomova, K.; Raptova, R.; Alomar, S.Y.; Alwasel, S.H.; Nepovimova, E.; Kuca, K.; Valko, M. Reactive oxygen species, toxicity, oxidative stress, and antioxidants: Chronic diseases and aging. Arch. Toxicol. 2023, 97, 2499–2574. [Google Scholar] [CrossRef]
- Kanofsky, J.R. Singlet Oxygen in Biological Systems: A Comparison of Biochemical and Photochemical Mechanisms for Singlet Oxygen Generation. In Oxygen Free Radicals in Tissue Damage; Tarr, M., Samson, F., Eds.; Birkhäuser: Boston, MA, USA, 1993. [Google Scholar]
- Escobar, M.A.; da Costa, D.M.; Trofymchuk, O.S.; Daniliuc, C.G.; Gracia, F.; Nachtigall, F.M.; Santos, L.S.; Rojas, R.S.; Cabrera, A.R. Intermolecular stabilization in new 2-iminopyridine derivatives complexes of Pd (II) and their reactivity towards alkenes. J. Organomet. Chem. 2018, 863, 21–29. [Google Scholar] [CrossRef]
- Ishida, H.; Tobita, S.; Hasegawa, Y.; Katoh, R.; Nozaki, K. Recent advances in instrumentation for absolute emission quantum yield measurements. Coord. Chem. Rev. 2010, 254, 2449–2458. [Google Scholar] [CrossRef]
- Sheldrick, G.M. SHELXT–Integrated space-group and crystal-structure determination. Acta Crystallogr. Sect. A Found. Adv. 2015, 71, 3–8. [Google Scholar] [CrossRef] [PubMed]
- Dolomanov, O.V.; Bourhis, L.J.; Gildea, R.J.; Howard, J.A.; Puschmann, H. OLEX2: A complete structure solution, refinement and analysis program. J. Appl. Crystallogr. 2009, 42, 339–341. [Google Scholar] [CrossRef]
- Sheldrick, G.M. Crystal structure refinement with SHELXL. Acta Crystallogr. Sect. C Struct. Chem. 2015, 71, 3–8. [Google Scholar] [CrossRef]
- Paterson, D.L.; Hujer, K.M.; Hujer, A.M.; Yeiser, B.; Bonomo, M.D.; Rice, L.B.; Bonomo, R.A.; International Klebsiella Study, G. Extended-spectrum beta-lactamases in Klebsiella pneumoniae bloodstream isolates from seven countries: Dominance and widespread prevalence of SHV- and CTX-M-type beta-lactamases. Antimicrob. Agents Chemother. 2003, 47, 3554–3560. [Google Scholar] [CrossRef]
- Boyd, D.A.; Tyler, S.; Christianson, S.; McGeer, A.; Muller, M.P.; Willey, B.M.; Bryce, E.; Gardam, M.; Nordmann, P.; Mulvey, M.R. Complete nucleotide sequence of a 92-kilobase plasmid harboring the CTX-M-15 extended-spectrum beta-lactamase involved in an outbreak in long-term-care facilities in Toronto, Canada. Antimicrob. Agents Chemother. 2004, 48, 3758–3764. [Google Scholar] [CrossRef]
- Sliney, D.H.; International Commission on Illumination. Radiometric quantities and units used in photobiology and photochemistry: Recommendations of the Commission Internationale de L’Eclairage (International Commission on Illumination). Photochem. Photobiol. 2007, 83, 425–432. [Google Scholar] [CrossRef]
- Huang, C.H.; Tsai, J.S.; Chen, I.W.; Hsu, B.R.; Huang, M.J.; Huang, Y.Y. Risk factors for in-hospital mortality in patients with type 2 diabetes complicated by community-acquired Klebsiella pneumoniae bacteremia. J. Formos. Med. Assoc. 2015, 114, 916–922. [Google Scholar] [CrossRef] [PubMed]
- Chuang, Y.P.; Fang, C.T.; Lai, S.Y.; Chang, S.C.; Wang, J.T. Genetic determinants of capsular serotype K1 of Klebsiella pneumoniae causing primary pyogenic liver abscess. J. Infect. Dis. 2006, 193, 645–654. [Google Scholar] [CrossRef]
- Cubero, M.; Grau, I.; Tubau, F.; Pallares, R.; Dominguez, M.A.; Linares, J.; Ardanuy, C. Hypervirulent Klebsiella pneumoniae clones causing bacteraemia in adults in a teaching hospital in Barcelona, Spain (2007–2013). Clin. Microbiol. Infect. 2016, 22, 154–160. [Google Scholar] [CrossRef]
- Padilla, E.; Llobet, E.; Domenech-Sanchez, A.; Martinez-Martinez, L.; Bengoechea, J.A.; Alberti, S. Klebsiella pneumoniae AcrAB efflux pump contributes to antimicrobial resistance and virulence. Antimicrob. Agents Chemother. 2010, 54, 177–183. [Google Scholar] [CrossRef] [PubMed]
- Spek, L. Single-crystal structure validation with the program PLATON. J. Appl. Cryst. 2003, 36, 7–13. [Google Scholar] [CrossRef]

| Bacteria | Gram Staining | NP as Nanocarrier | Microbial Eradication Rate | References |
|---|---|---|---|---|
| S. aureus | positive | MB-AuNP | 95.6% | [27] |
| S. aureus | Positive | Zr/Ti porphyyrinoid metal-organic | 99–100% | [28] |
| K. pneumoniae | Negative | MB-AuNP-ConA | 97% | [29] |
| Compounds | λab/nm | λem/nm | Φem |
|---|---|---|---|
| CuC1 | 380, 421, 460 | 600 | 0.038 |
| PSRu-L3 | 281, 428, 460 | 608 a | 0.156 a |
| Hep-G2 | HEK293 | ||
|---|---|---|---|
| PE | 17% | 22.3% | |
| SF | PS/NP | 0.87 ± 0.015 | 0.93 ± 0.010 |
| PDT | 0.86 ± 0.032 | 0.93 ± 0.036 |
| Primer Name | Primer Sequence | TM. | Amplicon Size | Origin |
|---|---|---|---|---|
| bla-SHV.SE | ATGCGTTATATTCGCCTGTG | 45 | 747 | [88] |
| bla-SHV.AS | TGCTTTGTTATTCGGGCCAA | 45 | ||
| TEM-164.SE | TCGCCGCATACACTATTCTCAGAATGA | 53 | 445 | [47] |
| TEM-165.AS | ACGCTCACCGGCTCCAGATTTAT | 52 | ||
| CTX-M-U1 | ATGTGCAGYACCAGTAARGTKATGGC | 54 | 593 | [89] |
| CTX-M-U2 | TGGGTRAARTARGTSACCAGAAYCAGCGG | 58 |
| Gene | Primers | Gene Type | Origen |
|---|---|---|---|
| oxyR | TCCCGAAGCTGGAAATGTAT | Oxidative and nitrosative stress transcriptional regulator | [50] |
| GAGCATAATAAGGCGAAAGA | |||
| sodA | TTCCGGCTTCCCGATTATCGGCCT | Superoxide dismutase | [50] |
| AGCTTCGTCCCAGTTCACTA | |||
| rpoE | AACGGGTCCAGAAAGGAGAT | Gene encoding the Sigma factor 32 | [50] |
| CCTGAACAACGTCAGCGATA | |||
| Hfq | ATGGCTAAGGGGCAATCTTT | Posttranscriptional regulation | [50] |
| GCTTGATACCATTCACCAAA | |||
| mrkD | AAGCTATCGCTGTACTTCCGGCA | Adhesin type 3 fimbriae | [91] |
| GGCGTTGGCGCTCAGATAGG | |||
| magA | GGTGCTCTTTACATCATTGC | Capsular serotype K1 and hypermucoviscosity phenotype | [92] |
| GCAATGGCCATTTGCGTTAG | |||
| rmpA | CATAAGAGTATTGGTTGACAG | Regulator of mucoid phenotype A | [93] |
| CTTGCATGAGCCATCTTTCA | |||
| acrB | GTAAACGTCGTTGGTTAGCC | Acriflavine resistance protein B | [94] |
| CTGTATGAGAGCTGGTCGAT | |||
| 16S rRNA | ATTTGAAGAGGTTGCAAACGAT | Gene encoding the 16S ribosomal RNA | [50] |
| TTCACTCTGAAGTTTTCTTGTGTTC |
Disclaimer/Publisher’s Note: The statements, opinions and data contained in all publications are solely those of the individual author(s) and contributor(s) and not of MDPI and/or the editor(s). MDPI and/or the editor(s) disclaim responsibility for any injury to people or property resulting from any ideas, methods, instructions or products referred to in the content. |
© 2025 by the authors. Licensee MDPI, Basel, Switzerland. This article is an open access article distributed under the terms and conditions of the Creative Commons Attribution (CC BY) license (https://creativecommons.org/licenses/by/4.0/).
Share and Cite
Hormazábal, D.B.; Reyes, Á.B.; Cuevas, M.F.; Bravo, A.R.; Costa, D.M.-d.; González, I.A.; Navas, D.; Brito, I.; Dreyse, P.; Cabrera, A.R.; et al. Photodynamic Effectiveness of Copper-Iminopyridine Photosensitizers Coupled to Zinc Oxide Nanoparticles Against Klebsiella pneumoniae and the Bacterial Response to Oxidative Stress. Int. J. Mol. Sci. 2025, 26, 4178. https://doi.org/10.3390/ijms26094178
Hormazábal DB, Reyes ÁB, Cuevas MF, Bravo AR, Costa DM-d, González IA, Navas D, Brito I, Dreyse P, Cabrera AR, et al. Photodynamic Effectiveness of Copper-Iminopyridine Photosensitizers Coupled to Zinc Oxide Nanoparticles Against Klebsiella pneumoniae and the Bacterial Response to Oxidative Stress. International Journal of Molecular Sciences. 2025; 26(9):4178. https://doi.org/10.3390/ijms26094178
Chicago/Turabian StyleHormazábal, Dafne Berenice, Ángeles Beatriz Reyes, Matías Fabián Cuevas, Angélica R. Bravo, David Moreno-da Costa, Iván A. González, Daniel Navas, Iván Brito, Paulina Dreyse, Alan R. Cabrera, and et al. 2025. "Photodynamic Effectiveness of Copper-Iminopyridine Photosensitizers Coupled to Zinc Oxide Nanoparticles Against Klebsiella pneumoniae and the Bacterial Response to Oxidative Stress" International Journal of Molecular Sciences 26, no. 9: 4178. https://doi.org/10.3390/ijms26094178
APA StyleHormazábal, D. B., Reyes, Á. B., Cuevas, M. F., Bravo, A. R., Costa, D. M.-d., González, I. A., Navas, D., Brito, I., Dreyse, P., Cabrera, A. R., & Palavecino, C. E. (2025). Photodynamic Effectiveness of Copper-Iminopyridine Photosensitizers Coupled to Zinc Oxide Nanoparticles Against Klebsiella pneumoniae and the Bacterial Response to Oxidative Stress. International Journal of Molecular Sciences, 26(9), 4178. https://doi.org/10.3390/ijms26094178

